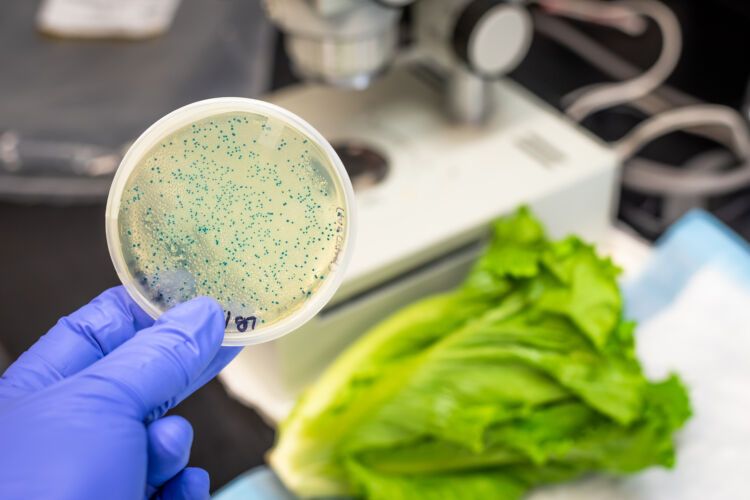

If you picked up a pre-made salad recently, drop the fork and back away. Fast.
The FDA has issued a Class I recall — its most urgent warning — on nearly 1,000 cases of deli salads that could be fatal. The salads, made by Isabelle’s Kitchen, Maple Avenue Foods, and Kings, have been linked to salmonella-contaminated cucumbers supplied by Florida-based Bedner Growers, Inc.
These aren’t just your average lunchtime regrets. Class I recalls mean “reasonable risk of death.” The infected salads were shipped to supermarkets across eight states, including Florida, Pennsylvania, and the Carolinas, between May 27 and June 1. The box codes to watch are 134, 135, and 136.
Affected products include:
- King’s Greek Pasta Salad
- MAF Crunchy Wheatberry Salad
- Powerhouse Wheatberry Salad Kit
- IKI Greek Pasta Salad
- MAF Quinoa Tabouli
While no illnesses have yet been reported from these specific salads, the bigger cucumber recall has already been linked to 26 infections across 15 states, including New York, Ohio, and California. The Salmonella strain found on Bedner’s farm matched those found in sick patients.
Salmonella isn’t just a bad bellyache. For kids under 5, seniors, and immunocompromised individuals, it can lead to sepsis, organ failure, and even death. Each year, over 400 Americans die from Salmonella.
The FDA warns that some salads may have been repacked in-store and not show the original date codes. Consumers are urged to return or destroy the products — no nibbling, no exceptions.
So if your fridge has a “fresh” salad from any of these brands, toss it.